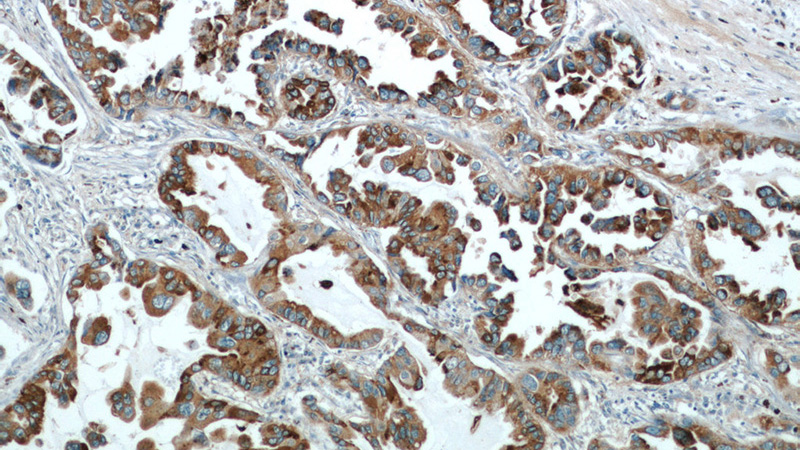
Immunohistochemical of paraffin-embedded human lung cancer using Catalog No:107321(NAPSA antibody) at dilution of 1:50 (under 10x lens)

-
Product Name
Napsin A antibody
- Documents
-
Description
Napsin A Mouse Monoclonal antibody. Positive IHC detected in human lung cancer tissue, human kidney tissue, human lung tissue, rat lung tissue. Positive IF detected in HUVEC cells. Observed molecular weight by Western-blot: 45 kDa
-
Tested applications
ELISA, IHC, IF
-
Species reactivity
Human,Mouse; other species not tested.
-
Alternative names
Asp 4 antibody; ASP4 antibody; Aspartyl protease 4 antibody; KAP antibody; Kdap antibody; NAP1 antibody; NAPA antibody; NAPSA antibody; Napsin 1 antibody; Napsin A antibody; napsin A aspartic peptidase antibody; Pronapsin A antibody; SNAPA antibody; TA01/TA02 antibody
-
Isotype
Mouse IgG1
-
Preparation
This antibody was obtained by immunization of Napsin A recombinant protein (Accession Number: NM_004851). Purification method: Protein G purified.
-
Clonality
Monoclonal
-
Formulation
PBS with 0.02% sodium azide and 50% glycerol pH 7.3.
-
Storage instructions
Store at -20℃. DO NOT ALIQUOT
-
Applications
Recommended Dilution:
IHC: 1:20-1:200
IF: 1:10-1:100
-
Validations
Immunohistochemical of paraffin-embedded human lung cancer using Catalog No:107321(NAPSA antibody) at dilution of 1:50 (under 10x lens)

Immunohistochemical of paraffin-embedded human lung cancer using Catalog No:107321(NAPSA antibody) at dilution of 1:50 (under 40x lens)

Immunofluorescent analysis of HUVEC cells using Catalog No:107321(NAPSA Antibody) at dilution of 1:25 and Rhodamine-Goat anti-Mouse IgG
-
Background
Napsin is found in two isoforms, napsin A and B, with highly homologous nucleotide sequences (91.2%). Napsin A appears to be a functional proteinase, predominantly expressed in lung and kidney. Napsin B is transcribed exclusively in cells related to the immune system and lacks an in-frame stop codon and is believed to be a pseudogene.(PMID:12698189). Napsin A is superior to TTF-1 in distinguishing primary lung ACA from other carcinomas (except kidney), particularly primary lung small cell carcinoma, and primary thyroid carcinoma.(PMID:22288963).
-
References
- Yuan J, Jiang B, Zhang A. Accelerated hepatocellular carcinoma development in CUL4B transgenic mice. Oncotarget. 6(17):15209-21. 2015.
Related Products / Services
Please note: All products are "FOR RESEARCH USE ONLY AND ARE NOT INTENDED FOR DIAGNOSTIC OR THERAPEUTIC USE"
